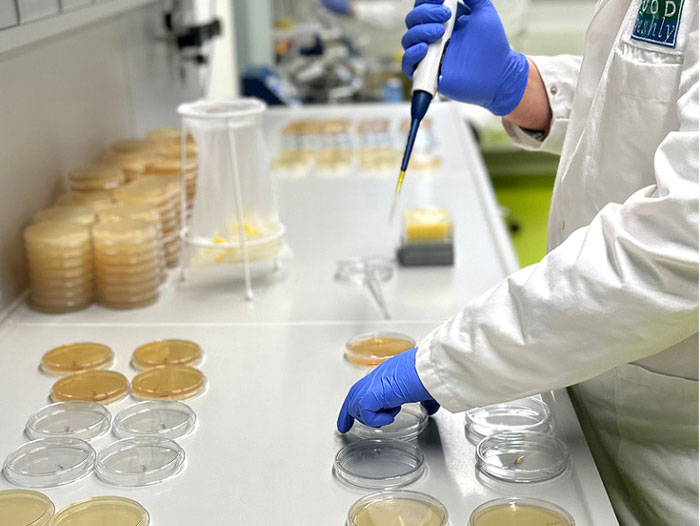

Fruit Logistica: FOOD freshly Kicks off 2024 With Two Ground-Breaking Innovations and a New Distribution Partnership
January 26, 2024 | 3 min to read
FOOD freshly, a leading expert in the field of fresh produce preservation, has announced the launch of two pioneering applications that have the potential to revolutionize the fresh-cut and processed produce industry. As part of Fruit Logistica 2024, the company will be presenting these significant advances at the largest trade fair for the fruit and vegetable trade.
To tackle the problem of premature oxidation in lettuce, FOOD freshly is introducing a pioneering application which extends the use of antioxidants in freshly harvested products. Using the new antioxidant prevents premature spoilage immediately after harvest, leading to a significant reduction in losses.
Now available for customers Europe-wide following successful in-field testing, this breakthrough in preservation technology enables farmers and processors to maintain the quality of their lettuce throughout the supply chain.
Developed to improve food safety when processing fruits and vegetables while avoiding the use of chemical disinfectants, FOOD freshly is also launching a new food washing process that boosts hygiene and helps preserve freshness. The system enables customers to eliminate the use of traditional disinfectants, such as chlorine and peracetic acid, as part of an innovative new means of delivering food-safe produce.
FOOD freshly’s Director of Technical Sales, Benjamin Singh, said: “Avoiding the use of traditional disinfectants will open up new opportunities, particularly in the European market. The process was developed to increase food safety during processing while preserving the freshness of the products.”
Singh said that processors interested in the new food hygiene processes are being invited to register for pilot trials.
Distribution partnership
Separately, FOOD freshly is pleased to announce that it has entered a new distribution partnership with Murre Technologies in the Netherlands. As part of a groundbreaking co-operation agreement, Murre Technologies will become FOOD freshly’s official distribution partner in the Netherlands and Belgium. This will enable even better support for customers in these regions.
Singh added: “We would like to cordially invite customers interested in learning more about these new developments to visit the FOOD freshly stand at Fruit Logistica in Berlin to find out how they can help your business and to exchange ideas with our experts.
“Through continuous research and development, FOOD freshly is committed to helping improve food safety in the fresh-cut sector. We look forward to welcoming new and existing customers at Fruit Logistica 2024 and shaping the future of fresh fruit and vegetable processing together.”
FOOD freshly will be exhibiting at Fruit Logistica 2024 in Hall 21, Stand E-40 from 7-9 February 2024.
For more information or to schedule an appointment for a personal meeting at Fruit Logistica 2024, please contact:
Benjamin Singh
benjamin.singh@food-freshly.eu
+49 521 96 8787 15
Food Freshly AFC GmbH
www.food-freshly.eu
